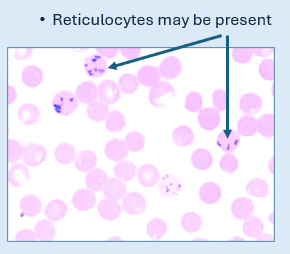
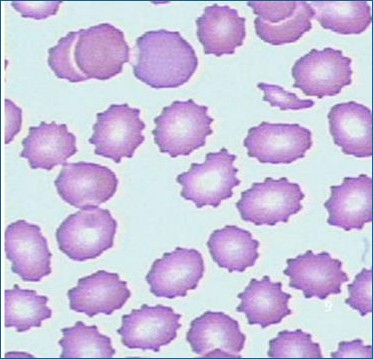
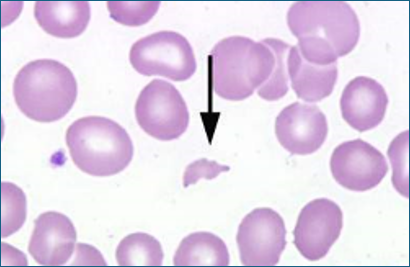
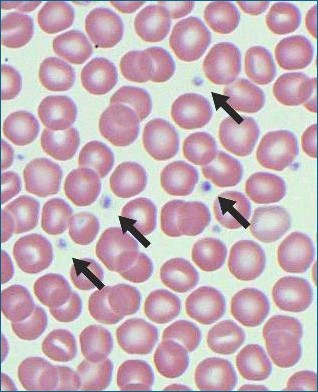

Haematology - Erythrocyte Morphology
1/20
Earn XP
Description and Tags
RBCs
Name | Mastery | Learn | Test | Matching | Spaced |
|---|
No study sessions yet.
21 Terms
Normal Canine and |Feline Erythrocyte Morphology
Anucleated
Circular
Biconcave in shape
Pink with a small area of central pallor
Size difference - Canine are slightly larger than feline
The most commonly seen morphological changes include:
Crenation
Schistocytes (resulting from Haemolysis)
Anisocytosis
Hypo and polychromasia
Autoagglutination
Rouleaux formation
Intracellular inclusions - Howell-Jolly Bodies, Heinz bodies, Babesia
Crenation looks like ..
Distorted, shrivelled and spikey appearance due to an osmotic shift causing it to shrivel
Crenation - known as ..
Echinocyte or Burr cells
When does crenation occur? And what is it the result from?
Occurs when there is a disruption in the cells ability to maintain its ionic state
Commonly resulting from inappropriate blood sampling, handling, storage and testing techniques e.g. use of aged blood sample, EDTA tubes that have not been sufficiently filled
Why might crenation occur from EDTA tubes not being filled sufficiently enough?
Too much anticoagulant can cause the osmotic change and causes the liquid in the cells to be drawn out
What is a Schistocyte?
A fragmented RBC that is a result of cell haemolysis (bursting of the cells)
What does a Schistocyte look like?
The cell swells and eventually burst
Which patients are Schistocytes seen?
Patients with immune mediated haemolytic anaemia (IMHA) - body starts to attack its own blood cells
What is the cause of a Schistocyte?
Inappropriate blood sample, handling, storage and testing techniques
What do Platelets (thrombocytes) look like?
Round/spindle shaped fragments of cytoplasm with no nucleus
What is Anisocytosis?
Where a patient has either larger than or smaller than normal RBCs
What are the subsections of Anisocytosis? And what do they mean?
Macrocytosis - Larger than normal RBCs
Microcytosis - Smaller than normal RBCs

Common causes of Anisocytosis ..
Regenerative anemia (In dogs)
Immune-mediated haemolytic anemia (IMHA)